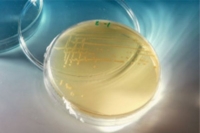

41
42
[43]
44
45

Следующая >>

Правительство Иркутской области заключило соглашение с Минсельхозом России о предоставлении субсидий
Между министерством сельского хозяйства Российской Федерации и Правительством Иркутской области заключено соглашение о предоставлении субсидий из федерального бюджета на поддержку сельхозтоваропроизводителей в 2016 году....

Почти 13 тыс. человек приняли участие в массовой лыжной гонке «Лыжня России» в Иркутской области
На старт XXXIV Всероссийской лыжной гонки «Лыжня России» в Иркутской области вышли 12 738 человек. В Иркутске гонка традиционно прошла на лыжной базе Иркутского...

Сидячий образ жизни ускоряет процесс старения мозга
Это выяснили ученые из Бостонского университета. В их исследовании приняли участие 1583 добровольца, не страдавших от деменции и болезней сердца. Средний возраст участников составлял...

К 2020 году Россия откажется от импортных продуктов
Министр сельского хозяйства Российской Федерации Александр Ткачев рассказал, что к 2020 году страна полностью откажется от импортных поставок молока, мяса и овощей. Такое заявление...

В Иркутской области пройдет акция «Потребитель, знай свои права!»
В Иркутской области с 25 февраля по 24 марта 2016 года пройдет акция «Потребитель, знай свои права!». Об этом сообщил руководитель службы потребительского рынка...
Бактерии обладают зрением, показало исследование
Исследователи изучают цианобактерии более 300 лет. И только сейчас они обнаружили у бактерий способность видеть. Ученые из Университета Фрайбурга и Университета Королевы Марии заметили,...

Ледовые провалы могут стоить жизни
Под лёд пролива Малого Моря провалился автомобиль Тойота Прадо, двое человек успели выбраться из машины. Ещё одного человека, передвигавшегося пешком по льду, спасатели ищут...

Крыши домов Иркутска очистят от снега и сосулек до 1 марта 2016г.
Как 10 февраля сообщила пресс-служба администрации города, такую задачу управляющим компаниям на внеочередном заседании городского штаба по вопросам ЖКХ поставил заместитель мэра - председатель...

41
42
[43]
44
45

Следующая >>



